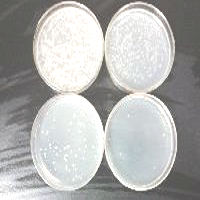
LB Lennox培養(yǎng)基粉劑

中文名:N6培養(yǎng)基
供應(yīng)商:上海遠慕
品牌:PhytoTech
保存:2-8℃保存
性狀:液體/粉末狀
規(guī)格: 250g
用途:適合于禾谷類植物的花藥和花粉培養(yǎng)
適用范圍:限于科研實驗,不作臨床。
N6培養(yǎng)基
配方:
硝酸鉀(KN03) :2830mg/l,硫酸銨(NH4SO4) :463mg/l,氯化鈣(CaCl2·2HzO) :166mg/l,硫酸鎂(MgSO4·7H20): 185mg/l;磷酸二氫鉀(KH2PO4): 400mg/l,硫酸亞鐵(FeSO4·7H20): 27.8mg/l,硫酸錳(MnS04·4H20) :4.4mg/l,硫酸鋅(ZnSO4·7H20): 1.6mg/l;
硼酸(H2BO3): 0.8mg/l,碘化鉀(KI) :1.6mg/l,甘氨酸:2mg/l,煙酸:0.5mg/l,鹽酸硫胺素(維B1): 1.0mg/l,鹽酸吡哆素(維B6) :0.5mg/l
保存方法:
1、干粉,買了后一定要保存在4度;有人保存在-20度,小編認為沒有必要,但4度是非常必要的,保證期是有提示的。
2、配好的無血清培養(yǎng)基一定保存在4度,保存不要超過3個月;用時根據(jù)提示要加入谷胺酰胺。
3、加入血清的培養(yǎng)基,最好保存在4度不要超過7個月,從時間太長,活性下降;當然稍微長點也不一定出問題,但是根據(jù)細胞而定;如果原代培養(yǎng),最好新鮮,如果是腫瘤細胞,或僅維持傳代就不太要緊;但是原則是越新越好。
適用范圍:
1、N6培養(yǎng)基特別適合于禾谷類植物的花藥和花粉培養(yǎng),在國內(nèi)外得到廣泛應(yīng)用。
2、在組織培養(yǎng)中,經(jīng)常采用的還有懷特(While,1963)培養(yǎng)基,尼許(Nitsch,1951)培養(yǎng)基等。
3、它們在基本成分上大同小異;懷特培養(yǎng)基由于無機鹽的數(shù)量比較低,更適合木本植物的組織培養(yǎng)。
實驗流程:
1、稱取本品 24.1g,加熱攪拌溶解于1000ml 蒸餾水中, 分裝三角瓶 115℃高壓滅菌 20 分鐘備用。注意:如果 pH 值偏低,請用稀氫氧化鈉調(diào)整pH值至5.8。
說明:
N6培養(yǎng)基是由我國朱至清等學(xué)者為水稻等禾谷類作物花藥培養(yǎng)而設(shè)計的;其特點是KNO3和(NH4)2SO4含量高,不含鉬;目前在國內(nèi)已廣泛應(yīng)用于小麥,水稻及其他植物的花粉和花藥培養(yǎng),增加2,4-D等植物生長素類似物之后還可以用于愈傷組織的誘導(dǎo)。
注意事項:
1、現(xiàn)在一般用通用鐵鹽代替草酸鐵。2、過磷酸鈣先用鹽酸溶解,再加入培養(yǎng)基中。
3、現(xiàn)在瓊脂質(zhì)量較好,具體用量,自己掌握。
4、用于蘭花播種和組織培養(yǎng),具有較好的緩沖能力。
5、為了您的健康和安全著想,請配帶工作服及手套。
6、請嚴格按照產(chǎn)品說明書要求進行規(guī)范性操作。
培養(yǎng)基相關(guān)咨訊推薦:
精子細胞BWW培養(yǎng)基儲存液
培養(yǎng)基配制過程中的注意事項
標簽:N6培養(yǎng)基
售前服務(wù):
產(chǎn)品介紹,技術(shù)疑難解答售中服務(wù):
守信合同,保證及時供貨,隨時保持與客戶聯(lián)系售后服務(wù):
1.對用戶所有疑問,快速做出反映,售后服務(wù)人員在2~3個工作日內(nèi)給您一個滿意的答復(fù)。2.產(chǎn)品如有質(zhì)量問題,遠慕實行包退、包換服務(wù)。
專業(yè)生產(chǎn)、專業(yè)服務(wù),遠慕為你創(chuàng)造更多價值
不斷提升服務(wù)質(zhì)量,精益求精,“真誠的服務(wù)”是遠慕永恒的主題。
遠慕生物訂購流程如下:
1、絕大部分產(chǎn)品備有現(xiàn)貨,一般情況下都能訂貨當日發(fā)貨。2、部分非常用產(chǎn)品,需提前1-2日預(yù)訂,海外期貨則需要提前3-6周預(yù)訂。
3、部分產(chǎn)品價格會因貨期、批次等因素發(fā)生變化,若有變動以訂貨當日價格為準。
4、每日訂單截止時間為18點整,部分城市可到19點整,因超過截止時間造成當日不能發(fā)貨的將于次日安排發(fā)貨。
5、請辦理完貨款后,將收據(jù)、底單等連同收貨人的地址、姓名、電話等以傳真、EMail、電話等形式通知我們。

基.jpg)

.jpg.jpg)
